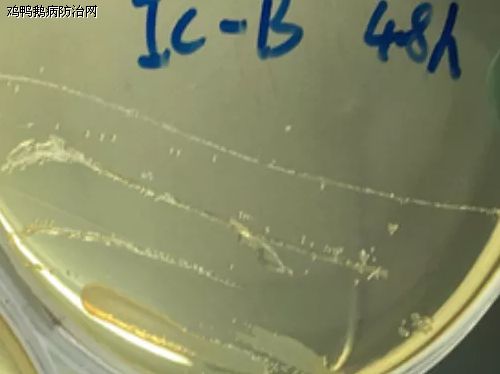

鸡鸭鹅病防治网联合驰骋祥兽医研究所共同分享:
传染性鼻炎是由副鸡嗜血杆菌(Hpg)引起的鸡急性上呼吸道感染的传染病,主要症状是面部肿胀,鼻道和鼻窦有粘液性分泌物。该病由于传播快,发病急、短期可感染整个鸡场而受到当前规模化鸡场的普遍重视。各种年龄鸡均可感染,4周龄以上易感性增强,其中育成鸡和产蛋鸡最易感染,使肉鸡肉质下降和产蛋鸡产蛋量明显下降(10%~40%),给养禽业造成巨大的经济损失。因此,对鸡传染性鼻炎进行准确鉴定,及时进行有效的处理和疫苗的免疫,可大幅度减少该病的损失。现将一例传染性鼻炎病例的诊断和防治体会总结如下,以供大家参考:
一、发病情况
广东某鸡场70多天龄鸡出现呼吸道症状,死亡率不高,眼结膜炎,头肿(见图1)。减料,死亡率0.2%/天,出栏残次率5%。之前使用治疗呼吸道及磺胺类药物,有一定疗效,停药复发。

图1 发病鸡面部肿胀和结膜炎
二、解剖症状
剖检可见鸡只眼部、脸部肿胀明显、皮下组织增厚水肿,眼结膜囊内有淡黄色的豆腐渣样分泌物,鼻腔和窦粘膜表面有水样、脓样粘液,鼻窦内有胶冻样凝块,气管环充血,出血,喉气管充血,喉头有纤维素性渗出物。
三、实验室诊断
1.细菌分离
取头消毒,无菌切开眶下窦,用接种环蘸取眶下窦内容物,在含有NAD(烟酰胺腺嘌呤二核苷酸)的鸡血清琼脂平板上划线,同时接种普通肉汤和普通琼脂平板作为对照,然后将平板翻转放于37℃、5%CO2的培养箱内培养16~48h。结果显示,普通肉汤和普通琼脂平板均无细菌生长,而在鸡血清琼脂平板上长有圆形、半透明露珠状菌落。
图2 在鸡血清琼脂平板上长有半透明、露珠状菌落
2、PCR鉴定
1)挑取上述鸡血清琼脂平板上的单个可疑菌落进行纯培养后,按常规方法处理细菌培养物,取2uL作模板用鸡传染性鼻炎特异性引物进行PCR检测。结果显示,细菌培养物为副鸡嗜血杆菌(见图3)。

图3 菌落培养物的特异性PCR电泳图
(M :DL1000 DNA Marker;1-细菌培养物;A+/B+/C+对应IC-A型、IC-B型、IC-C型阳性对照,“-”为阴性对照,阳性片段500bp)
2)用鸡传染性鼻炎分型引物进行PCR检测。结果显示,此株细菌为B型副鸡嗜血杆菌(见图4)。

图4 菌落培养物的分型PCR电泳图
(M :DL1000 DNA Marker;1-细菌培养物;A+/B+/C+对应IC-A型、IC-B型、IC-C型阳性对照,“-”为阴性对照,A型0.8kb,B型1.1kb,C型1.6kb)
四、初步诊断
根据发病情况、解剖症状和实验室检测结果,可初步诊断该鸡场发生传染性鼻炎。
五、病因分析
1、传染性鼻炎潜伏期短,传染迅速,发病率高,死亡率不定,病鸡及隐性带菌鸡是传染源,可通过飞沫、尘埃经呼吸道传染,也可通过饮水、饲料经消化道传播。
2、本病发生跟环境因素、对其他病毒性呼吸道疾病的及时防治、鸡的机体抵抗力也有很大关系,增强鸡的抗病力对防治本病有重要意义。


六、防治体会
1、治疗
鸡群用新力甲或泰灭清+好得快 兑水150公斤/瓶、驰骋EAD乳液兑水200公斤/瓶,新力爽兑水200公斤/包,连续饮用一周;同时饲料中添加0.5%碳酸氢钠按1公斤/吨,紧急接种传染性鼻炎灭活油苗0.5ml/只。现已过一个多月,末见有复发。
2、讨论和体会
1)传染性鼻炎的病鸡及隐性带菌鸡是传染源,鸡场务必做到全进全出的饲养方式,禽舍和设备进行清洗和消毒后,在重新饲养清洁鸡之前,禽舍应空闲2~3周。引种时不要引进不明来历的鸡只,老龄鸡容易感染和带菌,新进鸡群要远离老鸡群,人员不要频繁交叉进出新老鸡群。
2)加强鸡群的饲养管理,改善鸡舍通风条件,夏季做好防暑、冬季做好保温,给与多种维生素、氨基酸或电解质等保健物质,增强鸡的抗病力;做好鸡场的日常卫生消毒、舍内空气喷雾消毒和饮水消毒,有利于缩短病程和减轻发病症状。
3)治疗本病磺胺药是为首选,但不能根除病原菌,停药后常复发,除了隔离淘汰病鸡对鸡群及时治疗外,
4)紧急接种鼻炎灭活苗能有效防治复发。
5)推荐使用鼻炎灭活苗预防鸡的传染性鼻炎:在6周龄时首次免疫:颈部皮下注射0.25ml/只,12~14周龄时二次免疫0.5ml/只,可获得最佳免疫效果。

无抗养殖首选解决2问题:肠道病 霉菌病 等净化传染病的消毒模式:
1、改善水质、净化养殖环境:用驰骋一片净,每周三定期消毒一次,即可达到净化养殖环境目的(祛除棚舍氨气、空气净化首选--驰骋一片净(减少呼吸道疾病传播))。经过数百家养殖企业使用证明:选用驰骋一片净,消毒效果好!对多种病毒、细菌、真菌有效率达93%-98.5%。畜禽养殖防控肠道病好用、有效、实惠、方便、便宜等特点的产品--驰骋一片净(10000只鸡1天只需25-30元的药费即可解决病从口入)老养殖朋友都在用,您还在等什么............
2、杀灭真菌霉菌孢子、清除场地霉菌滋生:用驰骋克真霉,每半月定期饮水消毒一次,即可杀灭畜禽体内霉菌孢子、真菌孢子的生长;杀灭场地霉菌孢子的方法,建议每周至少在畜禽生长、活动的场地内喷雾消毒一次。
3、杀灭蚊蝇:每半月用驰骋蚊蝇一喷净或特制蚊虫一扫光,喷雾一次,即可减少舍内蚊蝇等传播媒介的滋生。
鸡鸭鹅病防治网为规模化养殖企业(场)提供疫病防控最佳解决方案!!!http://yangzhian880.blog.163.com/
禽病实战专家咨询:13939028068 (技术总监-魏老师 个人 微信:CC-zbs 欢迎交流)博客:http://blog.sina.com.cn/gallopsbj
养殖安、驰骋钙、新力爽等产品销售顾问:成龙在路上 13838248089 博客: http://lyrswcl.blog.163.com
来源:鸡鸭鹅病防治网 分享 http://www.jyebfz.com 中兽医 http://www.中兽医.com






发表评论共有0访客发表了评论
暂无评论,快来抢沙发吧!